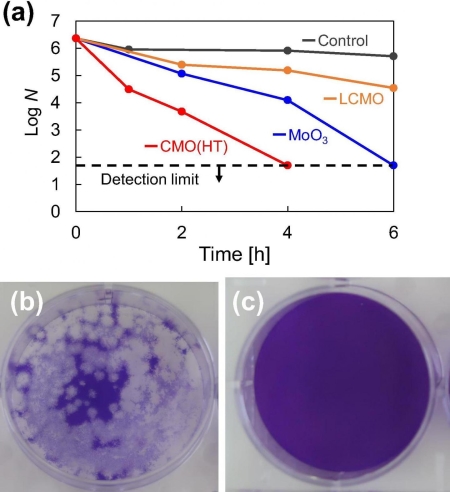

(a)制备出的粉末对冠状病毒的抗病毒活性,以及经过处理4小时后冠状病毒菌斑数目的变化 (b)对照组(c)使用CMO处理组
图片来源:《材料快报》(Material letters)
东京工业大学的研究人员与日本神奈川工业技术大学、奈良医科大学的同事合作,成功制备了一种名为钼酸铈(γ-Ce2Mo3O13或CMO)的材料,该材料对冠状病毒显示出很高的抗病毒活性。
持续的冠状病毒大流行不仅凸显了疫苗开发和推出的紧迫性,更强调了开发具有抗病毒特性的创新材料和技术的紧迫性,这些材料和技术可能在帮助遏制病毒传播等方面起着至关重要的作用。
常规的无机抗微生物材料通常由诸如铜的金属或诸如二氧化钛的光催化剂制备。但是,金属基材料容易腐蚀,而黑暗条件下,光催化剂的作用则受到限制。

图片来源:材料快报
现在,由东京工业大学材料科学与工程系的Akira Nakajima领导的研究团队提出了一种可以克服上述这些缺点的新型抗病毒材料。该团队成功地将一种成本相对较低的稀土元素铈(Ce)与以抗菌作用闻名的钼(Mo)相结合,制备了两种类型的钼酸铈粉末(Ce2Mo3O12和γ-Ce2Mo3O13)。
两种粉末均显示出对噬菌体Φ6的抗病毒活性。值得注意的是,γ-Ce2Mo3O13还表现出对SARS-CoV-2(引起COVID-19的病毒)的高抗病毒活性。
研究人员推断,铈与钼酸根离子的有效结合及其比表面积是有助于观察到的抗病毒活性的关键因素。
该研究建立在中岛刚领导的早期工作的基础上,其工作证明了由氧化镧和氧化钼组成的名为LMO(La2Mo2O9)的材料的抗病毒活性。然而,研究人员发现LMO对于抗非包膜型(噬菌体Qβ)病毒的活性要优于包膜型(噬菌体Φ6)病毒。随后的测试表明,将铈掺入材料中以制备La1.8Ce0.2Mo2O9 (LCMO),可提高其对噬菌体Φ6的抗病毒活性。这项非凡的发现激发了人们对钼酸铈(CMO)进一步研究的兴趣,钼酸铈(CMO)将成为一种对包膜型病毒(如流感病毒和SARS-CoV-2)具有高抗病毒活性的前景材料。

图片来源:Pixabay
为了获得接近单晶相的理想CMO粉末样品,研究小组进行了许多试验,然后通过可聚合络合物方法和水热处理分别成功制备了Ce2Mo3O12与γ-Ce2Mo3O13。
如果标准化并大量生产CMO,它可用于多种材料,例如树脂、纸张、薄膜和油漆。这将打开在高接触表面上使用CMO涂层的可能性,例如门把手、车辆内部的皮带、电梯按钮和自动扶梯带以及墙壁、瓷砖和窗户。Nakajima预计,结合了CMO的材料也可以用于智能手机和衣服等日常用品中。他指出,将CMO应用在眼镜和口罩等眼部和面部洁具可能需要更长的开发时间,但相关开发已在计划之中。
翻译:曾欣欣
审校:董子晨曦
引进来源:东京工业大学

本文来自:中国数字科技馆
特别声明:本文转载仅仅是出于科普传播信息的需要,并不意味着代表本网站观点或证实其内容的真实性;如其他媒体、网站或个人从本网站转载使用,须保留本网站注明的“来源”,并自负版权等法律责任;作者如果不希望被转载或其它相关事宜,请与我们接洽。
[责任编辑:环球科学]








京公网安备11010502039775号


